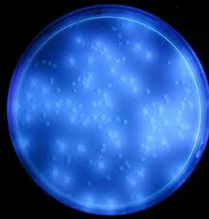

Laboratorio
El laboratorio está orientado a satisfacer las necesidades de ensayos de aguas, a particulares, profesionales, instituciones, establecimientos comerciales, recreacionales, industriales y de servicios.
Servicios adicionales de toma y retiro de muestras en la ciudad de Córdoba y gran Córdoba, como así también la recepción de muestras enviadas de cualquier punto del país, direcciones técnicas y asesoramiento.
ANÁLISIS DE AGUA MICROBIOLÓGICOS Y FISICOQUÍMICOS

Agua para consumo Humano:
- Ley 18284/69 Cap. XII C.A.A.
- Ley Higiene y Seguridad en el Trabajo.
- Normas Prov. de Calidad y Control de Agua Para Bebida de Cba.

Agua Envasada:
- Ley 18284/69 Cap. XII C.A.A.
- Agua de Mesa.
- Agua Mineral.

Agua para Piscinas:
- Ord. Municipal Córdoba. N° 1166/2008

Agua para uso Recreativo:
- C.O.N.A.M.A.

Agua para consumo Animal:
- S.E.N.A.S.A.

Agua para Riego:
- I.N.T.A.

Agua para uso Industrial:
- De Proceso: Cerveza, Hielo, etc.
- Calderas.
- Circuitos de refrigeración.

Efluentes (Industriales-Cloacales):
- Dto. 178 E 89 Ord. Mun. Cba. 7104
- Dto. 847 Ley Prov. Cba. 10208
ANÁLISIS AMBIENTALES
Ensayos microbiológicos Ambientales
- Salas de elaboración.
- Depósitos.
- Espacios de interés.

Validación Microbiológica
- B.P.M. Buenas Prácticas de Manufactura

Validación Microbiológica
- P.O.E.S. en superficies vivas (Procesos Operativos Estandarizados de saneamiento).

Validación Microbiológica
- P.O.E.S. en superficies inertes (Procesos Operativos Estandarizados de saneamiento).
DIRECCIONES TÉCNICAS
Destinado a plantas embotelladoras y fraccionadoras de agua, cooperativas de agua, instituciones recreativas (colonia de vacaciones, clubes, entre otras).

- Visitas de rutina semanales o quincenales (consultar otras preferencias).
- Elaboración de manuales de BPM.
- Controles de establecimiento.
- Elaboraciones de POES.
- Capacitación del personal.
ASESORAMIENTO

- Tratamientos de agua para consumo humano, industrial, recreativo.
- Instalación de plantas de agua.
OTROS SERVICIOS
Gestiones para obtención de RNE (Registro Nacional de Establecimiento) y RNPA (Registro Nacional de Producto Alimenticio.)
Gestiones para habilitación municipal.


Laboratorio Nicolás Echevarría e Hijos | Ombú 2180 Altos de Villa Cabrera (5009) Córdoba, Argentina. Teléfonos: 0351-152 333 797 | 0351-156 620 905 ing.echevarria@yahoo.com

Alcance: Laboratorio de ensayos microbiológicos y físico químicos de agua para consumo humano y animal, uso industrial, agrícola y recreacional, y ensayos de agua y efluentes residuales.